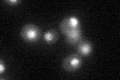
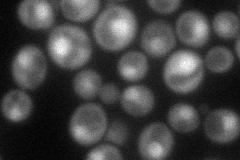
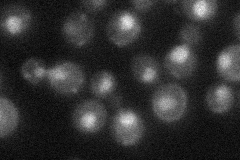
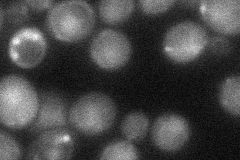
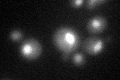
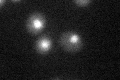

View description
GTPase component of U5 snRNP involved in mRNA splicing via spliceosome; binds directly to U5 snRNA; proposed to be involved in conformational changes of the spliceosome; similarity to ribosomal translocation factor EF-2
Localization:
Intensity:
Fold change:
Significance:
-
C’ GFP library in SD
nucleus34.47 -
N' NOP1pr-GFP in SD
cytosol,nucleus52.5443 -
N' TEF2pr-mCherry in SD

nucleus56.1257 -
N' NATIVEpr-GFP in SD
nucleus28.566 -
N' TEF2pr-VC and Cyto-VN in SD
cytosol,nucleus35.2691 -
C’ GFP library in SD+DTT
nucleus27.080.78No -
C’ GFP library in SD+H2O2

nucleus36.61.06No -
C’ GFP library in Starvation Media
nucleus30.350.88No -
C’ GFP library on the background of Pup2-DaMP

nucleus -
C’ GFP library on the background of CCT mutant

nucleus27.33430.792834No
